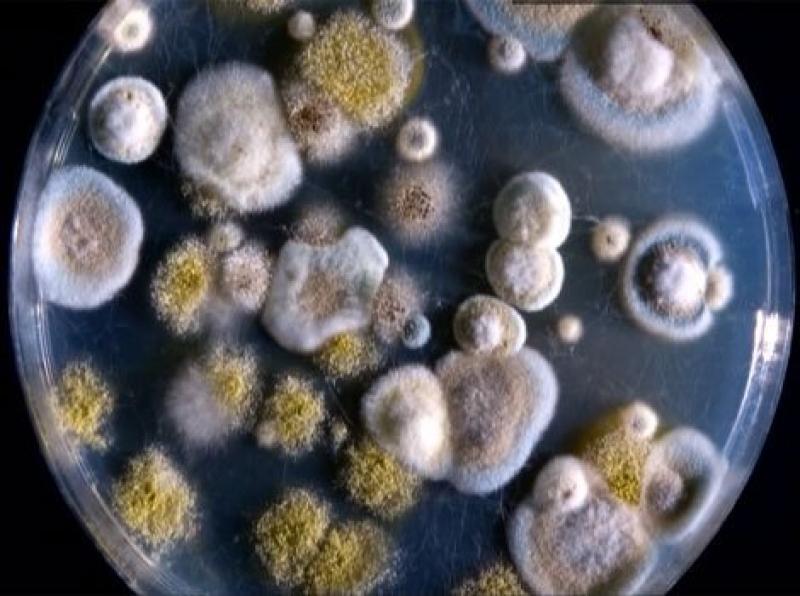
Грибки

В поисках способа для очистки внутренних органов люди принимают различные адсорбенты, способные не только вывести лишние токсины и шлаки, но и снизить вес. Полифепан для очищения организма часто применяется при заболеваниях пищеварительного тракта, склонности к аллергии, ожирении и других проблемах.
О препарате
Даже у абсолютно здорового человека в процессе жизнедеятельности скапливаются вредоносные бактерии, которые проникают в организм через еду, воду, а также с помощью окружающей среды. Полифепан относится к кишечным сорбентам, которые связывают на поверхности кишечника токсины различного происхождения, являющиеся основной причиной отравлений, снижения иммунитета и прочих недомоганий.
Средство производится в форме порошка темно-коричневого цвета и таблеток для внутреннего применения.
Основной активный компонент – лигнин гидролизный, содержащийся в водорослях и в клетках некоторых растений. Данное вещество используется как в медицинских целях, так и химическом производстве.
В коробке по 10, 50, 100, 250 г порошка или по 30, 50, 100, 200 таблеток.
Врачи отмечают, что полифепан, являясь сорбентом, может эффективно использоваться для очищения организма от токсинов и вредных веществ. Его способность связывать и выводить из организма различные яды и шлаки делает его популярным средством в детоксикационных программах. Однако специалисты подчеркивают, что применение полифепана должно быть обоснованным и контролируемым. Необходимо учитывать индивидуальные особенности пациента, а также возможные противопоказания. Врачи рекомендуют использовать полифепан в сочетании с другими методами очищения и поддержания здоровья, такими как правильное питание и физическая активность. Кроме того, важно соблюдать дозировку и продолжительность курса, чтобы избежать негативных последствий для организма.

Показания
Показаниями являются следующие патологические состояния:
- болезни пищеварительного тракта, приводящие к общей интоксикации;
- отравления различного происхождения;
- понос;
- вздутие живота, повышенное скопление газов;
- склонность к аллергическим реакциям;
- женские болезни;
- ожирение;
- атеросклероз;
- восстановительный период после лечения антибиотиками.
Чаще всего полифепан применяют как способ для очищения и похудения.
Попав в пищеварительную систему, активный компонент вступает во взаимодействие с желудочным соком, жидкостью и слизью, в результате чего лигнин разбухает и впитывает в себя патогенные бактерии, токсичные и ядовитые вещества, и естественно извлекает их наружу, приводя к уменьшению массы тела.
Во время вынашивания ребенка и в детском возрасте сорбент можно употреблять без опасений, однако дозировку для детей следует уменьшить вдвое. Средство является безопасным и назначается при пищевых интоксикациях, обострении инфекций кишечника, токсикозе. Полифепан устраняет тошноту, предупреждает рвотные рефлексы, положительно воздействует на весь пищеварительный тракт, возмещая нехватку пищевых волокон.
Очищение продолжают до устранения признаков отравления. Перед применением необходимо посоветоваться с лечащим врачом.
Свойства и терапевтическое действие
После употребления таблеток или порошка активный компонент проникает в органы ЖКТ, где связывает вредоносные микроорганизмы и выводит их естественным путем. Главным отличием от медикаментов, обладающих похожим воздействием, является то, что полифепан способен подавить:
Сорбент обладает мощным воздействием и при грамотном применении поможет устранить застарелые токсины, оказывающие медленное разрушительное влияние на организм, а также острые отравления.
Свойства медикамента заключаются в следующем:
- связывание шлаков и продуктов распада в кишечной системе;
- обезвреживание токсинов;
- извлечение их из организма;
- детоксикация.
Прием адсорбента приводит к значительному улучшению состояния пациента, очищению внутренних органов и восстановлению их физиологических процессов.
Препарат показал высокую активность в отношении:
- медикаментов;
- ядов различного происхождения;
- солей металлов;
- спиртных напитков и их метаболитов;
- аммиака;
- холестериновых бляшек;
- радиоактивных изотопов;
- аллергенов и других соединений.
Часто назначается полифепан при отравлении, спровоцированном лекарствами, химическими веществами, при пищевых интоксикациях. Средство не всасывается в кровеносную систему и лимфу, локализуется в кишечнике и выводится спустя 24 часа после орального употребления.
После применения данного лекарства натурального происхождения не возникает побочных эффектов в виде дисбактериоза.
Полифепан, как средство для очищения организма, вызывает множество обсуждений среди пользователей. Многие отмечают его эффективность в устранении токсинов и шлаков, что, по их мнению, способствует улучшению общего самочувствия. Люди делятся положительными впечатлениями о снижении симптомов аллергии и улучшении состояния кожи после курса применения. Однако не все отзывы однозначны: некоторые пользователи сообщают о неприятных побочных эффектах, таких как вздутие живота и дискомфорт в желудке. Важно отметить, что перед началом приема полифепана рекомендуется проконсультироваться с врачом, чтобы избежать нежелательных реакций и подобрать оптимальную дозировку. В целом, полифепан продолжает оставаться популярным средством для детоксикации, и его применение активно обсуждается в различных форумах и группах.

Как поможет препарат для очищения
Полифепан обладает достаточно универсальными фармакологическими свойствами, выступая не только как сорбент, но и как средство для очищения, похудения и выведения токсинов.
Медикамент работает в следующих направлениях:
- поглощает яды;
- избавляет от интоксикации;
- устраняет диарею;
- снижает уровень холестерина в крови;
- обладает антиоксидантными свойствами.
Благотворно воздействуя на кишечную микрофлору, препарат восполняет нехватку естественных волокон в организме и обладает эффектом, в несколько раз превышающим действие активированного угля.
Кроме того, проникая в организм, полифепан стимулирует функционирование печени, почек, дыхательных путей и кишечника, что положительно отражается на протекании заболевания и общем самочувствии.
Чистка сорбентом поможет человеку устранить большое скопление токсинов на поверхности кишечной системы. Профилактическое очищение проводят 3-4 раза в год на протяжении 14 дней.
Рекомендуемая доза составляет 3-4 таблетки в день либо 1 столовая ложка порошка 4 раза в день. Обязательным условием является употребление большого количества воды: это поможет уменьшить вероятность запоров и облегчить процесс извлечения шлаков из внутренних органов.
Регулярно употребляя сорбент полифепан, можно вывести токсины, очистить кровеносную систему и плазму.
Очистка полифепаном применяется с целью похудения: средство способно компенсировать нехватку пищевых волокон, что способствует утрате чувства голода и стимуляции работы кишечника.
Своевременное очищение кишечника от патогенных микроорганизмов и вредных веществ способствует укреплению иммунной системы, нормализации липидного обмена. Особенно актуальны данные свойства для людей, принимающих сорбент для похудения, а также лиц, чья работа связана с физической нагрузкой.
Как проводить очищение
В основе очищающего курса является удаление вредных веществ и избавление от зашлакованности. За несколько дней до проведения очищающих мероприятий с помощью Полифепана необходимо скорректировать свой рацион.
В диету следует включить:
- растительную пищу;
- овощи;
- фрукты;
- каши из круп;
- супы.
Однако чистка сорбентом может привести к тому, что вместе с вредными бактериями извлекутся полезные микроэлементы, содержащиеся в кишечнике. Поэтому дополнительно необходимо употреблять следующие продукты:
- пророщенную пшеницу;
- морскую капусту;
- чеснок;
- отруби;
- а также большое количество воды.
Длительность очищения составляет 9-10 дней. Полифепан пьют за 60 минут до еды, по 10 г порошка, разведенного в 100 г воды. Употреблять препарат 4 раза в сутки. Таблетки употребляют по 3-4 штуки в день, запивая водой. Кроме того, во время детоксикации необходимо проводить очищение клизмой. На 2 л воды – 1 столовая ложка уксуса, 2 столовые ложки свекольного сока. Клизму применяют дважды за курс.

Для похудения
Энтеросорбент нередко применяется с целью устранить излишний вес, однако мгновенного результата от приема препарата ждать не стоит. Полифепан устраняет вредные вещества, нормализует процесс пищеварения, восстанавливает моторику кишечника, благотворно воздействует на жировой обмен, отвечающий за набор массы тела. За счет этого и происходит уменьшение веса.
Чтобы действие сорбента было максимально эффективным, необходимо придерживаться строгой диеты.
Для снижения массы тела и очистки организма от ненужных веществ средство принимают в стандартной дозировке. Курс очищения не должен превышать 2 недель.
От прыщей
Различные угревые высыпания и прыщи на коже часто указывают на расстройство функционирования пищеварительной системы, а также наличие большого количества шлаков в организме, которые проявляются через кожные покровы.
Средство эффективно в отношении прыщей, возникших на фоне употребления сладостей, соленых блюд, жареной пищи, жирных продуктов, спиртных напитков, а также при пищевой аллергии. Курс очистки от прыщей составляет 10-14 дней, после чего делают перерыв на 14 дней. При необходимости повторяют процедуру.
Употреблять разведенный порошок следует по одной столовой ложке четырежды в сутки или 3-4 таблетки 4 раза в день между едой. Чтобы усилить терапевтическое действие, совместно с ним назначаются витаминные комплексы, содержащие цинк и минеральные вещества, а также употребляют не менее 1,5 литра воды в сутки.
При аллергии
Аллергическую реакцию невозможно устранить исключительно полифепаном, однако сорбент поможет усилить действие других лекарств и косметических средств.
Препарат успешно связывает и извлекает аллергены, провоцирующие образование аллергии. Применяя полифепан, можно предупредить рецидив аллергической реакции, а также купировать последующий всплеск аллергии.
Кроме того, принимая порошок или таблетки, можно увеличить длительность ремиссии и уменьшить выраженность признаков аллергии.
Противопоказания и побочные эффекты
Средство запрещено употреблять:
- при наличии индивидуальной непереносимости действующего вещества;
- во время запоров;
- при диабете 2-го типа;
- при анацидном гастрите;
- при язвенном поражении ЖКТ в стадии обострения;
- при ухудшении перистальтики кишечника.
Негативные действия после приема полифепана возникают крайне редко. Обычно последствия выражаются в виде запора и аллергии на активное вещество. При появлении данных состояний необходимо прекратить лечение и заменить сорбент другим средством.
Употребление препарата более 20 дней подряд может привести к нехватке витаминов и микроэлементов, поэтому во время использования необходимо принимать витаминно-минеральные комплексы, содержащие кальций.
Очистка полифепаном чаще всего приводит к положительным результатам. Многие пациенты отмечают восстановление работы кишечника, улучшение общего состояния, исчезновение угревой сыпи и прыщей, а также потерю лишнего веса. Однако процедуру следует проводить после консультации со специалистом, а также соблюдая строгую диету.
Вопрос-ответ
Как принимать Полифепан для очистки кишечника?
Для детей от 1 года до 7 лет: по 0, 5-1 десертной ложке 2-4 раза в сутки. От 7 до 14 лет: по 1 столовой ложке 2-4 раза в сутки. Детям от 14 лет и взрослым: по 1-2 столовых ложки 3-4 раза в сутки. Длительность лечения при острых состояниях 3-5 дней, при аллергических заболеваниях и хронических интоксикациях до 14 дней.
Что лучше активированный уголь или Полифепан?
Активированный уголь – общеизвестный и доступный энтеросорбент. Сегодня в номенклатуре аптеки числится большое количество более эффективных сорбирующих препаратов, в том числе Полифепан. Лигнин из состава превосходит активированный уголь по сорбционной способности в 2500 раз.
Какие заболевания лечит Полифепан?
Полифепан применяют в качестве детоксицирующего средства при экзогенных и эндогенных токсикозах различного происхождения. Для оказания первой помощи при острых отравлениях лекарственными препаратами, алкалоидами, солями тяжёлых металлов, алкоголем и другими ядами.
Что чистит Полифепан?
Аллергических заболеваниях и аллергодерматозах, нарушениях жирового и других видов обмена, при хронических заболеваниях печени, почечной недостаточности и атеросклерозе, артрозе, подагре, остеохондрозе, гнойном перитоните.
Советы
СОВЕТ №1
Перед началом применения полифепана обязательно проконсультируйтесь с врачом. Это поможет избежать возможных противопоказаний и побочных эффектов, особенно если у вас есть хронические заболевания или вы принимаете другие лекарства.
СОВЕТ №2
Следуйте рекомендациям по дозировке и длительности курса, указанным в инструкции или предписанных врачом. Полифепан следует принимать в строго определенных количествах, чтобы достичь максимального эффекта и минимизировать риск негативных последствий.
СОВЕТ №3
Обратите внимание на режим питья во время курса очищения. Увеличьте потребление воды, чтобы помочь организму выводить токсины и поддерживать нормальное функционирование почек и печени.
СОВЕТ №4
После завершения курса полифепана рекомендуется провести восстановление микрофлоры кишечника с помощью пробиотиков. Это поможет избежать дисбаланса и улучшить общее состояние организма после очищения.